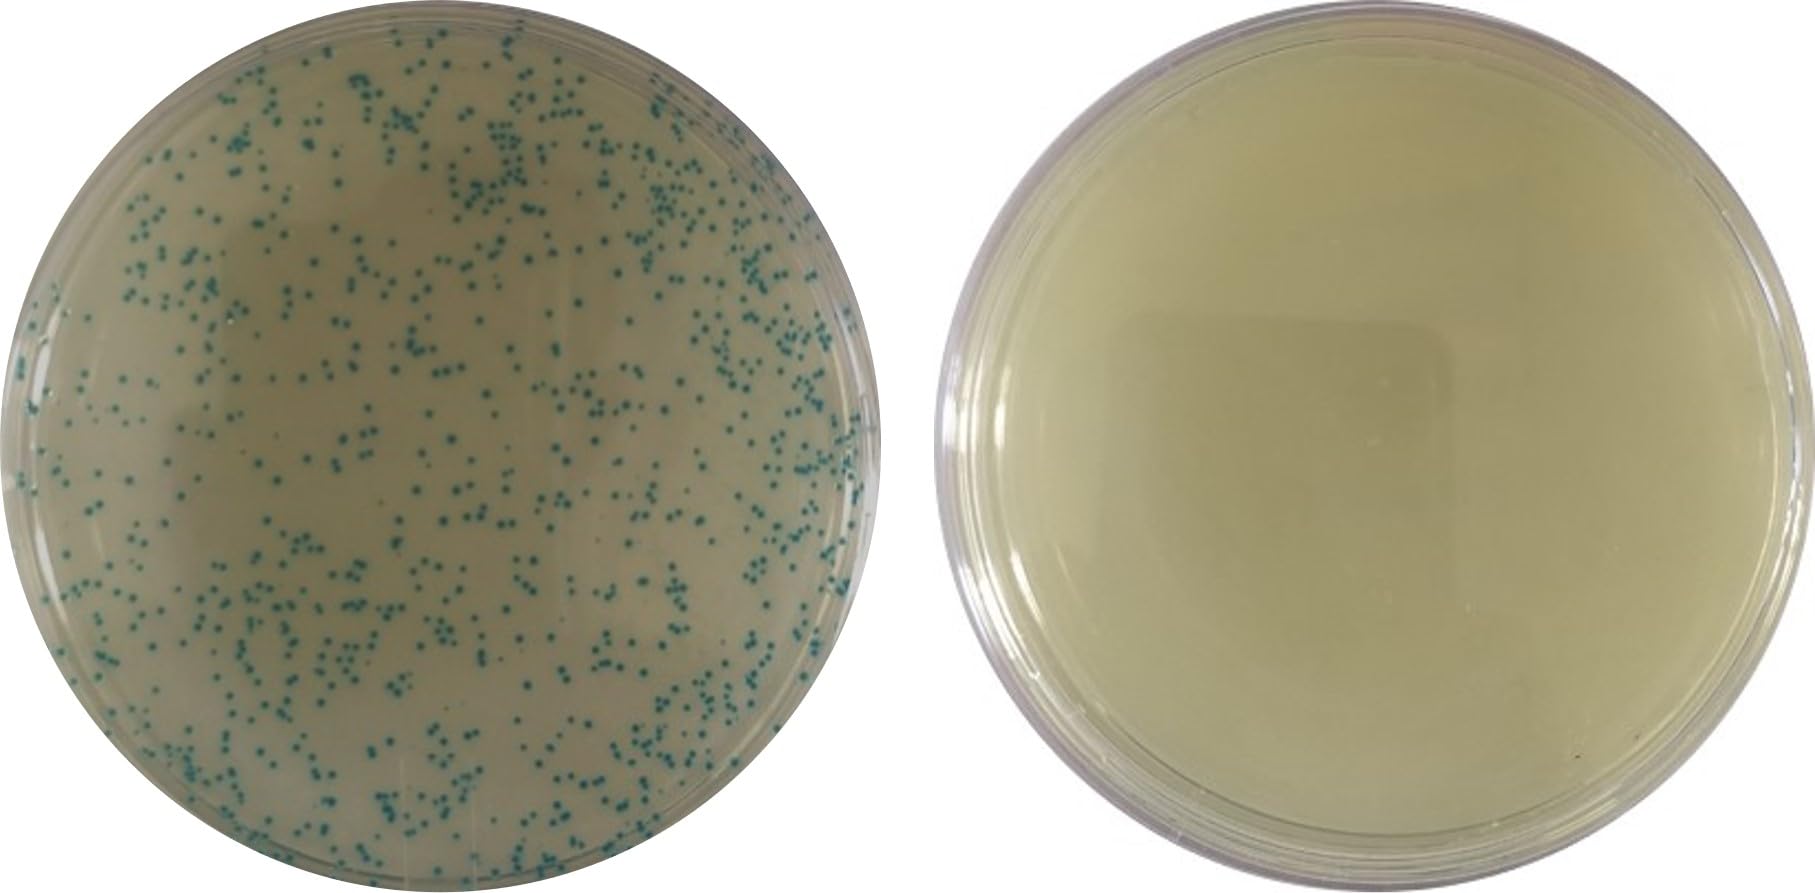
Bacterial Transformation Teaching Kit (10 Prep)

Customer Services
Copyright © 2025 Desertcart Holdings Limited
Desert Online General Trading LLC
Warehouse # 7, 4th Street, Umm Ramool, Dubai, 30183, Dubai

Bacterial Transformation Teaching Kit (10 Prep)
Trustpilot
2 days ago
3 days ago
3 days ago
2 weeks ago